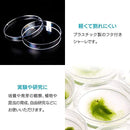
00ff00ff00ff02cf10ff00ff00ff00ffffffffffff7ffff7ff7ffff3fff1ffbb

お客様へのおすすめ商品
お客様が閲覧した商品
注意事項
■領収書・納品書の発行について
■ お客様ご自身で発行をお願いしております。発送時のメールに発行方法を記載しておりますのでご確認をお願い致します。
※宛名と但し書きのみ、ご指定が可能です。
※宛名をご指定いただく場合、記号(株式会社の記号など)は避けて下さい。
※紙面による発行・商品お届け時の同梱・郵送での対応は行っておりません。予めご了承ください。
※ 他ネットショップでも併売しているため、ご注文後に在庫切れとなる場合があります。予めご了承ください。
※ お使いのモニタにより写真の色が実際の商品の色と異なる場合や、イメージに差異が生じることがあります。予めご了承ください。
※ 商品の詳細(カラー・数量・サイズ 等)については、ページ内の商品説明をご確認のうえ、ご注文ください。
※ モバイル版・スマホ版ページでは、お使いの端末によっては一部の情報が表示されないことがあります。すべての記載情報をご確認するには、PC版ページをご覧ください。
■ お客様ご自身で発行をお願いしております。発送時のメールに発行方法を記載しておりますのでご確認をお願い致します。
※宛名と但し書きのみ、ご指定が可能です。
※宛名をご指定いただく場合、記号(株式会社の記号など)は避けて下さい。
※紙面による発行・商品お届け時の同梱・郵送での対応は行っておりません。予めご了承ください。
※ 他ネットショップでも併売しているため、ご注文後に在庫切れとなる場合があります。予めご了承ください。
※ お使いのモニタにより写真の色が実際の商品の色と異なる場合や、イメージに差異が生じることがあります。予めご了承ください。
※ 商品の詳細(カラー・数量・サイズ 等)については、ページ内の商品説明をご確認のうえ、ご注文ください。
※ モバイル版・スマホ版ページでは、お使いの端末によっては一部の情報が表示されないことがあります。すべての記載情報をご確認するには、PC版ページをご覧ください。